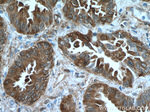
HSP27 Antibody in Immunohistochemistry (Paraffin) (IHC (P))

Search
Proteintech
HSP27 Polyclonal Antibody
{{$productOrderCtrl.translations['antibody.pdp.commerceCard.promotion.promotions']}}
{{$productOrderCtrl.translations['antibody.pdp.commerceCard.promotion.viewpromo']}}
{{$productOrderCtrl.translations['antibody.pdp.commerceCard.promotion.promocode']}}: {{promo.promoCode}} {{promo.promoTitle}} {{promo.promoDescription}}. {{$productOrderCtrl.translations['antibody.pdp.commerceCard.promotion.learnmore']}}
产品信息
18284-1-AP
种属反应
已发表种属
宿主/亚型
分类
类型
抗原
偶联物
形式
浓度
规格
纯化类型
保存液
内含物
保存条件
运输条件
产品详细信息
Immunogen sequence: MTERRVPFS LLRGPSWDPF RDWYPHSRLF DQAFGLPRLP EEWSQWLGGS SWPGYVRPLP PAAIESPAVA APAYSRALSR QLSSGVSEIR HTADRWRVSL DVNHFAPDEL TVKTKDGVVE ITGKHEERQD EHGYISRCFT RKYTLPPGVD PTQVSSSLSP EGTLTVEAPM PKLATQSNEI TIPVTFESRA QLGGPEAAKS DETAAK (1-205 aa encoded by B C012768)
靶标信息
In response to adverse changes in their environment, cells from many organisms increase the expression of a class of proteins referred to as heat shock or stress proteins. HSPB1 (heat shock protein beta-1 or HSP27) is a small heat shock protein which functions as a molecular chaperone that maintains denatured proteins in a folding-competent state. It plays a role in stress resistance and actin organization. Through its molecular chaperone activity, HSP27 regulates numerous biological processes including the phosphorylation and the axonal transport of neurofilament proteins. Mutations in the gene can result in Charcot-Marie-Tooth disease 2F and Neuronopathy distal hereditary motor 2B.
仅用于科研。不用于诊断过程。未经明确授权不得转售。
生物信息学
蛋白别名: 27-kda heat shock protein; 28 kDa heat shock protein; DKFZp586P1322; epididymis secretory protein Li 102; Estrogen-regulated 24 kDa protein; Growth-related 25 kDa protein; Heat shock 25 kDa protein; Heat shock 27 kDa protein; heat shock 27kD protein 1; heat shock 27kDa protein 1; Heat shock protein; Heat shock protein beta-1; Heat shock protein family B member 1; heat shock protein, 25 kDa; HS; HSP; HSP 25; HSP 27; HSP27; HSPB1; p25; Phospho-HSP 27; SRP27; Stress-responsive protein 27; truncated hsp25; unnamed protein product
基因别名: 27kDa; CMT2F; HEL-S-102; HMN2B; HMND3; HS.76067; Hsp25; HSP27; HSP28; HSPB1; SRP27
UniProt ID: (Human) P04792, (Mouse) P14602
Entrez Gene ID: (Human) 3315, (Mouse) 15507, (Rat) 24471